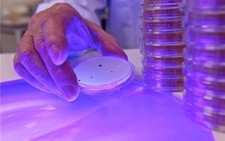

|
| Răng sữa là nguồn tế bào gốc quan trọng |
Theo PGS.TS Trần Lê Bảo Hà (trưởng bộ môn Sinh lí học và Công nghệ sinh học Động vật, Khoa Sinh học và Công nghệ sinh học, trường ĐH KHTN TP.HCM), ưu điểm vượt trội của tế bào gốc từ tủy răng đó là mỗi người đều có 20 cái răng sữa và có thể lấy hết một cách tự nhiên mà không cần sự can thiệp nhiều từ y tế. Mỗi răng sau 3 tuần nuôi cấy có thể cho ra 10 triệu tế bào.
Đến nay đã có hơn 1.000 công trình nghiên cứu ứng dụng tế bào gốc tuỷ răng được công bố trên thế giới. Các nghiên cứu cho thấy tế bào gốc từ tủy răng có khả năng biệt hóa thành các tế bào chuyên biệt để chữa các bệnh về răng, bệnh tiểu đường loại 1, bệnh tim mạch, các bệnh về gan, cơ, xương, thần kinh, giác mạc và chữa lành vết thương trên da.
Đặc biệt, so với các loại tế bào gốc khác như tế bào gốc từ tủy xương, mô mỡ… thì tế bào gốc từ tủy răng có khả năng biệt hóa thành tế bào gốc thần kinh vượt trội hơn hẳn.
 |
| PGS. TS Lê Bảo Hà hy vọng năm 2017 sẽ thực hiện được kế hoạch thành lập ngân hàng lưu trữ tế bào gốc từ tuỷ răng sữa - Ảnh: Ngọc Loan |
Quá trình lấy tế bào gốc từ răng sữa được thực hiện từ việc lấy răng khi em bé được đưa đến nha sĩ. Khi lấy răng, nha sĩ phải đảm bảo có chân răng thì mới nuôi cấy tế bào gốc được.
Nha sĩ lấy răng sữa xong thì cho vào bảo quản trong môi trường chuyên biệt để mang đi nuôi cấy. Từ khi lấy răng đến khi đưa đến phòng thí nghiệm, nếu được bảo quản đúng thì có thể để qua đêm.
Sau đó, răng sẽ được đưa đến phòng thí nghiệm để phân lập, nuôi cấy, xác định khả năng sống, khả năng tăng sinh của tế bào. Nếu có thể nuôi cấy thì tế bào sẽ được đưa vào ngân hàng để bảo quản lạnh trong môi trường nitơ lỏng.
Chi phí lưu trữ tế bào gốc tuỷ răng trên thế giới hiện dao động tùy theo các ngân hàng. Đắt nhất là 2.000 USD cho các bước thu nhận, phân lập, định danh tế bào gốc. Sau đó, chi phí bảo quản hàng năm vào khoảng 120 USD.
PGS.TS Trần Lê Bảo Hà Trường ĐH KHTN TP.HCM và Trường ĐH Y Dược TP.HCM đã lên kế hoạch để năm 2017 sẽ thành lập ngân hàng lưu trữ tế bào gốc từ tủy răng sữa. Hiện nhóm nghiên cứu hợp tác giữa hai trường đã được Cục sở hữu trí tuệ Việt Nam cấp Bằng độc quyền giải pháp hữu ích về "Quy trình nuôi cấy mô tủy răng người để thu nhận tế bào gốc".

Bình luận hay